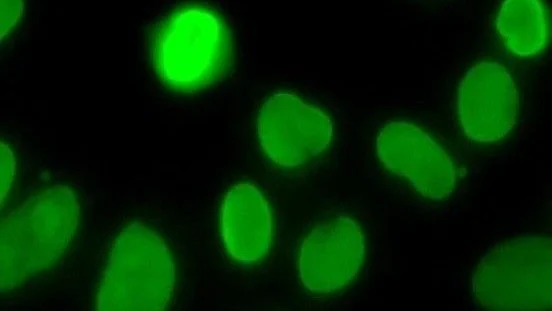
Streamline Your Assay Validation and QC Processes – Plasma Services Group

Plasma Services Group/LinkedIn
Mar 14, 2026, 17:05
Streamline Your Assay Validation and QC Processes – Plasma Services Group
Plasma Services Group shared a post on LinkedIn:
“Developing cutting-edge autoimmune diagnostics?
Precision is everything. PSG offers specialized, data-rich resources to streamline your assay validation and QC processes:
- HEp-2 Standard and Advanced Panels: Standardize your testing with diverse, well-characterized HEp-2 patterns.
- DFS70 Positive Patient Cohort: Deepen your marker knowledge with meticulous clinical data.
- APS Biobank Cohort: Comprehensive autoantibody profiles for Antiphospholipid Syndrome research.
Partner with us to secure the reliable external QC sera your lab needs.”
Stay updated on all scientific advances in the field of fertility with Fertility News.
-
Jun 19, 2026, 15:54Horace Roman: Sciatic Nerve Endometriosis – Prevent Muscle Atrophy Caused by Progressive Denervation
-
Jun 19, 2026, 15:36Why Does the Clock Read Older? – Fertility Plus
-
Jun 19, 2026, 15:28Asma Khalil: Study Raises Questions About Workplace Activities and Early Pregnancy Outcomes
-
Jun 19, 2026, 15:21Spindle Dynamics and Chromosome Segregation In Human Preimplantation Embryos – Fertility and Sterility
-
Jun 19, 2026, 15:12Today is World Sickle Cell Day – Preeclampsia Foundation
-
Jun 19, 2026, 14:59Marco Zaccaria: ESGE Webinar to Spotlight Advances in the Surgical Management of Parametrial Endometriosis
-
Jun 19, 2026, 14:46PMOS Does Not Make Conception Impossible – PCOS Awareness Association
-
Jun 19, 2026, 14:40Diana Kayal: Successful Fertility Programs Aren’t Built On Clinical Expertise Alone
-
Jun 19, 2026, 14:29Devyanshi Dixit: Call for Abstracts at GFWH 2026
